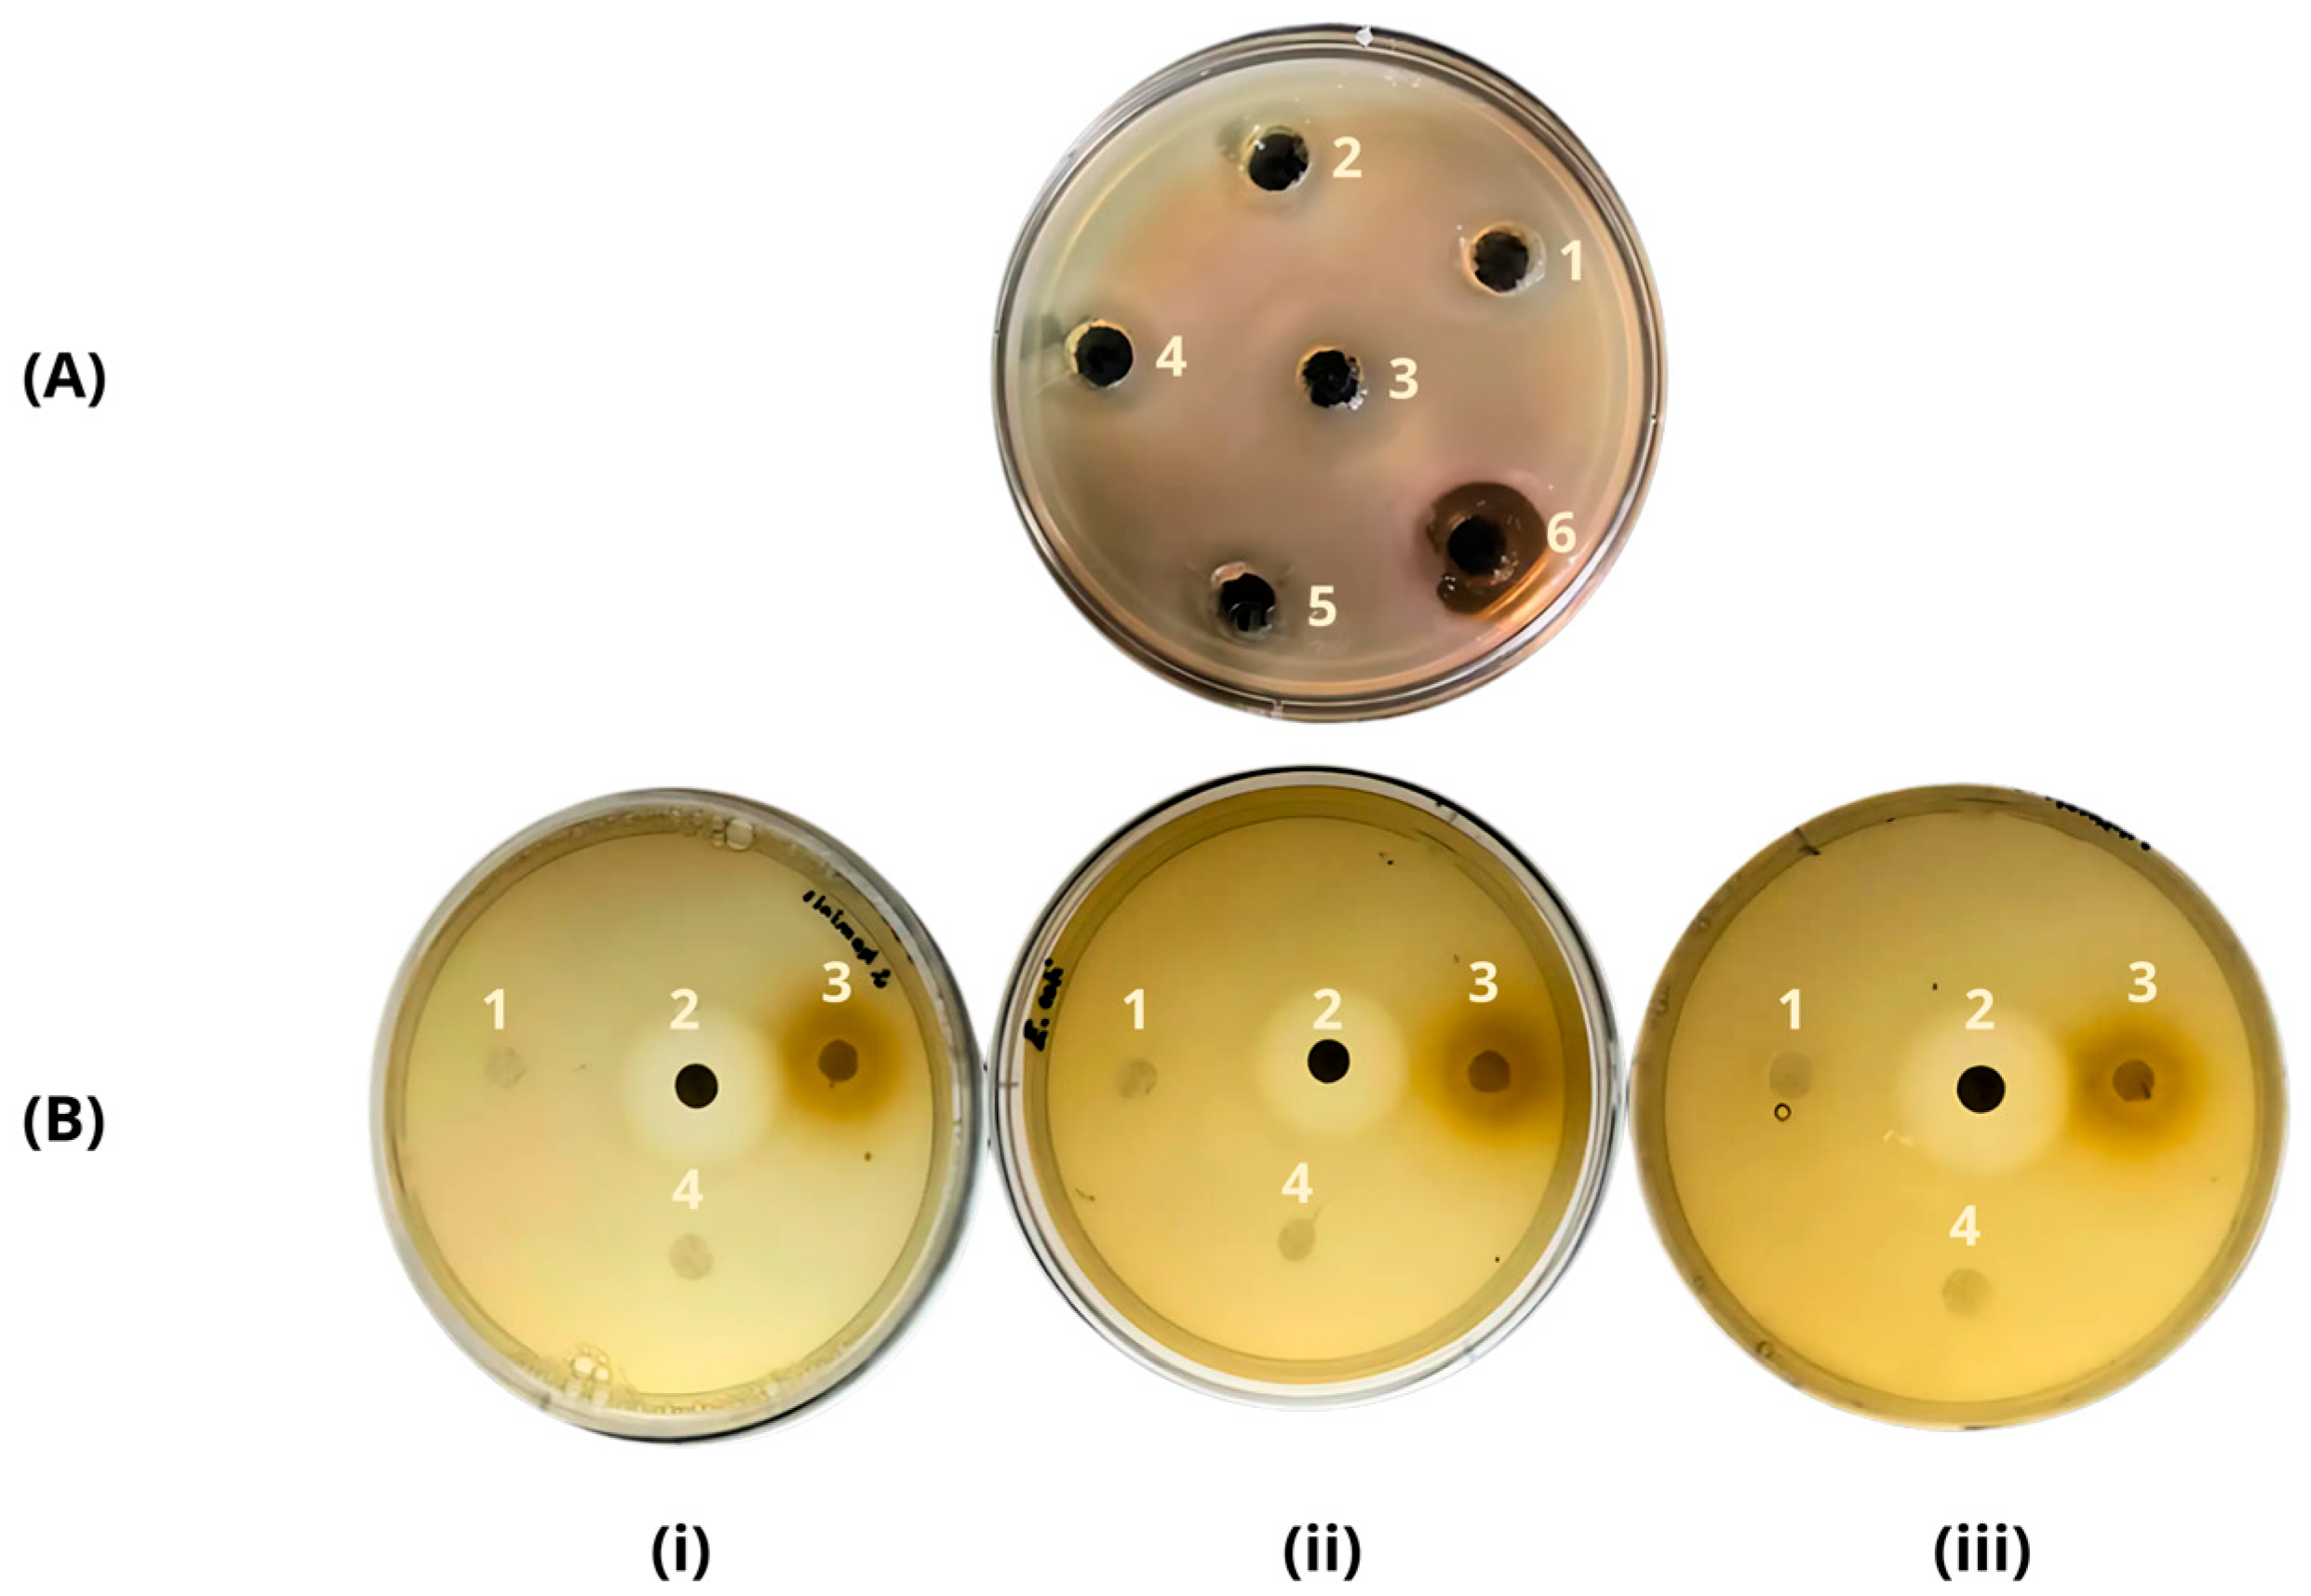
Materials 17 04705 g002

Design and Characterization of an Antimicrobial Biocomposite for Wound Dressings
Abstract
1. Introduction
2. Materials and Methods
2.1. Production of Antimicrobial Extract
2.2. Determination of Antimicrobial Activity
2.3. Preparation of Biocomposite with Antimicrobial Extract (BAE)
2.4. Physico-Mechanical Characterization of the Biocomposite
2.5. Moisture Absorption
2.6. Water Vapor Permeability (WVP)
3. Results and Discussion
3.1. Evaluation of Antimicrobial Activity of the Extract and BAE
3.2. Physico-Mechanical Properties: Elastic Modulus
3.3. Tensile Strength
3.4. Elongation at Break
3.5. Morphology (SEM)
3.6. Moisture Absorption and Water Vapor Permeability (WVP)
4. Conclusions
Author Contributions
Funding
Institutional Review Board Statement
Informed Consent Statement
Data Availability Statement
Acknowledgments
Conflicts of Interest
References
- Grennhalgh, R.; Dempsey-Hibbert, N.; Vagg-Whitehead, K. Antimicrobial Strategies and Economic Considerations for Polymeric Medical Implants. Int. Biodeterior. Biodegrad. 2019, 136, 1–14. [Google Scholar] [CrossRef]
- Homaeigohar, S.; Boccaccini, A.R. Antibacterial Biohybrid Nanofibers for Wound Dressings. Acta Biomater. 2020, 107, 25–49. [Google Scholar] [CrossRef] [PubMed]
- Mouro, C.; Dunne, C.P.; Gouveia, I.C. Designing New Antibacterial Wound Dressings: Development of a Dual Layer Cotton Material Coated with Poly (Vinyl Alcohol)-chitosan Nanofibers Incorporating Agrimonia eupatoria L. Extract. Molecules 2020, 26, 83. [Google Scholar] [CrossRef]
- Naseri-Nosar, M.; Ziora, Z.M. Wound dressings from naturally-occurring polymers: A review on homopolysaccharide-based composites. Carbohydr. Polym. 2018, 189, 379–398. [Google Scholar] [CrossRef] [PubMed]
- ASTM D6400; Standard Specification for Labeling of Plastics Designed to Be Aerobically Composted in Municipal or Industrial Facilities. American Society for Testing and Materials: West Conshohocken, PA, USA, 2003; pp. 1–3.
- Janik, W.; Nowotarski, M.; Ledniowska, K.; Shyntum, D.Y.; Krukiewicz, K.; Turczyn, R.; Sabura, E.; Furgoł, S.; Kudła, S.; Dudek, G. Modulation of Physicochemical Properties and Antimicrobial Activity of Sodium Alginate Films through the Use of Chestnut Extract and Plasticizers. Sci. Rep. 2023, 13, 11530. [Google Scholar] [CrossRef]
- Gámez-Herrera, E.; García-Salinas, S.; Salido, S.; Sancho-Albero, M.; Andreu, V.; Perez, M.; Lujan, L.; Irusta, S.; Arruebo, M.; Mendoza, G. Drug-Eluting Wound Dressings Having Sustained Release of Antimicrobial Compounds. Eur. J. Pharm. Biopharm. 2020, 152, 327–339. [Google Scholar] [CrossRef]
- Matica, M.A.; Aachmann, F.L.; Tøndervik, A.; Sletta, H.; Ostafe, V. Chitosan as a Wound Dressing Starting Material: Antimicrobial Properties and Mode of Action. Int. J. Mol. Sci. 2019, 20, 5889. [Google Scholar] [CrossRef]
- Unnithan, A.R.; Pichiah, P.B.T.; Gnanasekaran, G.; Seenivasan, K.; Barakat, N.A.M.; Cha, Y.-S.; Jung, C.-H.; Shanmugam, A.; Kim, H.Y. Emu Oil-Based Electrospun Nanofibrous Scaffolds for Wound Skin Tissue Engineering. Colloids Surf. A Physicochem. Eng. Asp. 2012, 415, 454–460. [Google Scholar] [CrossRef]
- Op’t Veld, R.C.; Walboomers, X.F.; Jansen, J.A.; Wagener, F.A. Design Considerations for Hydrogel Wound Dressings: Strategic and Molecular Advances. Tissue Eng. Part B Rev. 2020, 26, 230–248. [Google Scholar] [CrossRef]
- Sharma, A.; Verma, C.; Mukhopadhyay, S.; Gupta, A.; Gupta, B. Development of Sodium Alginate/Glycerol/Tannic Acid Coated Cotton as Antimicrobial System. Int. J. Biol. Macromol. 2022, 216, 303–311. [Google Scholar] [CrossRef]
- Khan, A.; Xu, M.; Wang, T.; You, C.; Wang, X.; Ren, H.; Zhou, H.; Khan, A.; Han, C.; Li, P. Catechol Cross-Linked Antimicrobial Peptide Hydrogels Prevent Multidrug-Resistant Acinetobacter Baumannii Infection in Burn Wounds. Biosci. Rep. 2019, 39, BSR20190504. [Google Scholar] [CrossRef] [PubMed]
- Summa, M.; Russo, D.; Penna, I.; Margaroli, N.; Bayer, I.S.; Bandiera, T.; Athanassiou, A.; Bertorelli, R. A Biocompatible Sodium Alginate/Povidone Iodine Film Enhances Wound Healing. Eur. J. Pharm. Biopharm. 2018, 122, 17–24. [Google Scholar] [CrossRef] [PubMed]
- Asif, M.; Rahman, K.A.; Faisal, M.O.; Islam, M.S. Comparative Study on Mechanical Properties of Bamboo and Bamboo-Glass Fiber Reinforced Hybrid Composites. J. Eng. Adv. 2020, 1, 6–10. [Google Scholar] [CrossRef]
- Osorio Vélez, L.S. Preparación y Caracterización de Un Sustituto Óseo Inyectable de Hidroxiapatita/Biopolímero/Tetraciclina Para Ingeniería de Tejidos Del Complejo Maxilofacial. Master’s Thesis, Universidad Nacional de Colombia, Medellín, Colombia, 2018. [Google Scholar]
- González, J.; Escobar, D.M.; Ossa, C.P. Producción y Caracterización de Cuerpos Porosos de Hidroxiapatita Sintética. Rev. Fac. Ing. Univ. Antioq. 2008, 43, 59–66. [Google Scholar]
- ASTM D638-03; Standard Test Method for Tensile Properties of Plastics. American Society for Testing and Materials: West Conshohocken, PA, USA, 2021; pp. 1–17.
- ASTM D570; Standard Test Method for Water Absorption of Plastics. American Society for Testing and Materials: West Conshohocken, PA, USA, 2022; pp. 1–14.
- ASTM E96; Standard Test Methods for Gravimetric Determination of Water Vapor Transmission Rate of Materials. American Society for Testing and Materials: West Conshohocken, PA, USA, 2024; pp. 1–16.
- Hu, Y.; Topolkaraev, V.; Hiltner, A.; Baer, E. Measurement of Water Vapor Transmission Rate in Highly Permeable Films. J. Appl. Polym. Sci. 2001, 81, 1624–1633. [Google Scholar] [CrossRef]
- Sunaryanto, R.; Lentaya, H.O.; Putra, I.; Rudiyono, R.; Damayanti, E.; Wahono, S.K.; Basuki, W. Isolation and Characterization of Bacteriocin Produced by Lactobacillus Plantarum Derived Indonesian Traditional Fermented Buffalo Milk. In Proceedings of the AIP Conference Proceedings, Bogor, Indonesia, 24–25 November 2022. [Google Scholar]
- Veettil, V.N. Optimization of Bacteriocin Production by Lactobacillus Plantarum Using Response Surface Methodology. Cell. Mol. Biol. 2022, 68, 105–110. [Google Scholar] [CrossRef]
- Jiang, Y.-H.; Xin, W.-G.; Zhang, Q.-L.; Lin, L.-B.; Deng, X.-Y. A Novel Bacteriocin against Shigella Flexneri from Lactiplantibacillus Plantarum Isolated from Tilapia Intestine: Purification, Antibacterial Properties and Antibiofilm Activity. Front. Microbiol. 2022, 12, 779315. [Google Scholar] [CrossRef] [PubMed]
- Huidrom, S.; Ngashangva, N.; Khumlianlal, J.; Sharma, K.C.; Mukherjee, P.K.; Devi, S.I. Genomic Insights from Lactiplantibacillus Plantarum BRD3A Isolated from Atingba, a Traditional Fermented Rice-Based Beverage and Analysis of Its Potential for Probiotic and Antimicrobial Activity against Methicillin-Resistant Staphylococcus Aureus. Front. Microbiol. 2024, 15, 1357818. [Google Scholar] [CrossRef]
- Goel, A.; Halami, P.M. Structural and Biosynthetic Diversity of Plantaricins from Lactiplantibacillus. Appl. Microbiol. Biotechnol. 2023, 107, 5635–5649. [Google Scholar] [CrossRef]
- Diep, D.B.; Straume, D.; Kjos, M.; Torres, C.; Nes, I.F. An Overview of the Mosaic Bacteriocin Pln Loci from Lactobacillus Plantarum. Peptides 2009, 30, 1562–1574. [Google Scholar] [CrossRef]
- Londoño, N.A.; Taborda, M.T.; López, C.A.; Acosta, L.V. Bacteriocinas Producidas Por Bacterias Ácido Lácticas y Su Aplicación En La Industria de Alimentos. Alimentos Hoy 2015, 23, 186–205. [Google Scholar]
- El Hamzaoui, N.; Barguigua, A.; Larouz, S.; Maouloua, M. Epidemiology of Burn Wound Bacterial Infections at a Meknes Hospital, Morocco. New Microbes New Infect. 2020, 38, 100764. [Google Scholar] [CrossRef]
- Garcia-Gonzalez, N.; Battista, N.; Prete, R.; Corsetti, A. Health-Promoting Role of Lactiplantibacillus Plantarum Isolated from Fermented Foods. Microorganisms 2021, 9, 349. [Google Scholar] [CrossRef]
- Jiang, L.; Li, Y.; Xiong, C.; Su, S.; Ding, H. Preparation and Properties of Bamboo Fiber/Nano-Hydroxyapatite/Poly (Lactic-Co-Glycolic) Composite Scaffold for Bone Tissue Engineering. ACS Appl. Mater. Interfaces 2017, 9, 4890–4897. [Google Scholar] [CrossRef] [PubMed]
- Zhang, K.; Wang, F.; Liang, W.; Wang, Z.; Duan, Z.; Yang, B. Thermal and Mechanical Properties of Bamboo Fiber Reinforced Epoxy Composites. Polymers 2018, 10, 608. [Google Scholar] [CrossRef] [PubMed]
- Mousavi, S.R.; Zamani, M.H.; Estaji, S.; Tayouri, M.I.; Arjmand, M.; Jafari, S.H.; Nouranian, S.; Khonakdar, H.A. Mechanical Properties of Bamboo Fiber-Reinforced Polymer Composites: A Review of Recent Case Studies. J. Mater. Sci. 2022, 57, 3143–3167. [Google Scholar] [CrossRef]
- Eslami, Z.; Elkoun, S.; Robert, M.; Adjallé, K. A Review of the Effect of Plasticizers on the Physical and Mechanical Properties of Alginate-Based Films. Molecules 2023, 28, 6637. [Google Scholar] [CrossRef]
- Wirawan, R.; Sapuan, S.M.; Robiah, Y.; Khalina, A. Elastic and Viscoelastic Properties of Sugarcane Bagasse-Filled Poly (Vinyl Chloride) Composites. J. Therm. Anal. Calorim. 2011, 103, 1047–1053. [Google Scholar] [CrossRef]
- Césare, M.F.; Hilario, F.; Callupe, N.; Cruz, L.; Calle, J.L.; Gonzales, H. Caracterización Química y Física Del Bambú. Av. Cienc. Ing. 2019, 10, 1–13. [Google Scholar]
- Abourehab, M.A.S.; Rajendran, R.R.; Singh, A.; Pramanik, S.; Shrivastav, P.; Ansari, M.J.; Manne, R.; Amaral, L.S.; Deepak, A. Alginate as a Promising Biopolymer in Drug Delivery and Wound Healing: A Review of the State-of-the-Art. Int. J. Mol. Sci. 2022, 23, 9035. [Google Scholar] [CrossRef]
- Bonifacio, A.; Bonetti, L.; Piantanida, E.; De Nardo, L. Plasticizer Design Strategies Enabling Advanced Applications of Cellulose Acetate. Eur. Polym. J. 2023, 197, 112360. [Google Scholar] [CrossRef]
- Paul, U.C.; Fragouli, D.; Bayer, I.S.; Zych, A.; Athanassiou, A. Effect of Green Plasticizer on the Performance of Microcrystalline Cellulose/Polylactic Acid Biocomposites. ACS Appl. Polym. Mater. 2021, 3, 3071–3081. [Google Scholar] [CrossRef]
- Bocqué, M.; Voirin, C.; Lapinte, V.; Caillol, S.; Robin, J.-J. Petro-Based and Bio-Based Plasticizers: Chemical Structures to Plasticizing Properties. J. Polym. Sci. A Polym. Chem. 2016, 54, 11–33. [Google Scholar] [CrossRef]
- Szatkowski, P.; Gralewski, J.; Suchorowiec, K.; Kosowska, K.; Mielan, B.; Kisilewicz, M. Aging Process of Biocomposites with the PLA Matrix Modified with Different Types of Cellulose. Materials 2023, 17, 22. [Google Scholar] [CrossRef]
- Alventosa Carbó, J. Efecto de La Incorporación de Antimicrobianos En La Biodegradación y Compostaje de Films Activos Para El Envasado de Alimentos. Bachelor’s Thesis, Universitat Politècnica de València, València, Spain, 2020. [Google Scholar]
- Azucena Castro-Yobal, M.; Contreras-Oliva, A.; Saucedo-Rivalcoba, V.; Rivera-Armenta, J.L.; Hernández-Ramírez, G.; Salinas-Ruiz, J.; Herrera-Corredor, A. Evaluation of Physicochemical Properties of Film-Based Alginate for Food Packing Applications. e-Polymers 2021, 21, 82–95. [Google Scholar] [CrossRef]
- Savencu, I.; Iurian, S.; Porfire, A.; Bogdan, C.; Tomuță, I. Review of Advances in Polymeric Wound Dressing Films. React. Funct. Polym. 2021, 168, 105059. [Google Scholar] [CrossRef]
- Daniels, P.H. A Brief Overview of Theories of PVC Plasticization and Methods Used to Evaluate PVC-Plasticizer Interaction. J. Vinyl Addit. Technol. 2009, 15, 219–223. [Google Scholar] [CrossRef]
- Goyal, S.; Hernández, N.B.; Cochran, E.W. An Update on the Future Prospects of Glycerol Polymers. Polym. Int. 2021, 70, 911–917. [Google Scholar] [CrossRef]
- Rios, J.A.T.; Mendoza, L.A.C.; Reyes, J.L.T. Comparative Study of the Mechanical Properties of the Polyester Resin Reinforced with Bamboo Fiber as the Substitute Material Fiberglass. DYNA Rev. Fac. Minas Univ. Nac. Colomb. Sede Medellín 2017, 84, 35–41. [Google Scholar]
- Pedraza Castañeda, M.; Pérez Jiménez, G.; Solís Flores, L.; Barrera Arenas, J.E.; Hernández Jiménez, P.; Xochigua Angulo, M.; Meléndez Mier, G. Coste-Efectividad de La Terapia Avanzada Con Productos de Cura En Ambiente Húmedo Comparada Con Terapia Tradicional En El Tratamiento de Úlceras Por Presión de Categorías I y II. Gerokomos 2021, 32, 199–204. [Google Scholar] [CrossRef]
- Kanjanamosit, N.; Muangnapoh, C.; Phisalaphong, M. Biosynthesis and Characterization of Bacteria Cellulose–Alginate Film. J. Appl. Polym. Sci. 2010, 115, 1581–1588. [Google Scholar] [CrossRef]
- Popescu, M.-C.; Dogaru, B.-I.; Popescu, C.-M. The Influence of Cellulose Nanocrystals Content on the Water Sorption Properties of Bio-Based Composite Films. Mater. Des. 2017, 132, 170–177. [Google Scholar] [CrossRef]
- Cernencu, A.I.; Lungu, A.; Dragusin, D.; Serafim, A.; Vasile, E.; Ionescu, C.; Iovu, H. Design of Cellulose–Alginate Films Using PEG/NaOH Aqueous Solution as Co-Solvent. Cellulose 2017, 24, 4419–4431. [Google Scholar] [CrossRef]
- Muraille, L.; Pernes, M.; Habrant, A.; Serimaa, R.; Molinari, M.; Aguié-Béghin, V.; Chabbert, B. Impact of Lignin on Water Sorption Properties of Bioinspired Self-Assemblies of Lignocellulosic Polymers. Eur. Polym. J. 2015, 64, 21–35. [Google Scholar] [CrossRef]

Disclaimer/Publisher’s Note: The statements, opinions and data contained in all publications are solely those of the individual author(s) and contributor(s) and not of MDPI and/or the editor(s). MDPI and/or the editor(s) disclaim responsibility for any injury to people or property resulting from any ideas, methods, instructions or products referred to in the content. |
© 2024 by the authors. Licensee MDPI, Basel, Switzerland. This article is an open access article distributed under the terms and conditions of the Creative Commons Attribution (CC BY) license (https://creativecommons.org/licenses/by/4.0/).
Share and Cite
Becerril-Serna, L.; Aguilar-Uscanga, B.R.; Flores-Soto, M.; Solís-Pacheco, J.R.; Cisneros-López, E.O. Design and Characterization of an Antimicrobial Biocomposite for Wound Dressings. Materials 2024, 17, 4705. https://doi.org/10.3390/ma17194705
Becerril-Serna L, Aguilar-Uscanga BR, Flores-Soto M, Solís-Pacheco JR, Cisneros-López EO. Design and Characterization of an Antimicrobial Biocomposite for Wound Dressings. Materials. 2024; 17(19):4705. https://doi.org/10.3390/ma17194705
Chicago/Turabian StyleBecerril-Serna, Leslie, Blanca Rosa Aguilar-Uscanga, Mario Flores-Soto, Josué Raymundo Solís-Pacheco, and Erick Omar Cisneros-López. 2024. "Design and Characterization of an Antimicrobial Biocomposite for Wound Dressings" Materials 17, no. 19: 4705. https://doi.org/10.3390/ma17194705
APA StyleBecerril-Serna, L., Aguilar-Uscanga, B. R., Flores-Soto, M., Solís-Pacheco, J. R., & Cisneros-López, E. O. (2024). Design and Characterization of an Antimicrobial Biocomposite for Wound Dressings. Materials, 17(19), 4705. https://doi.org/10.3390/ma17194705

